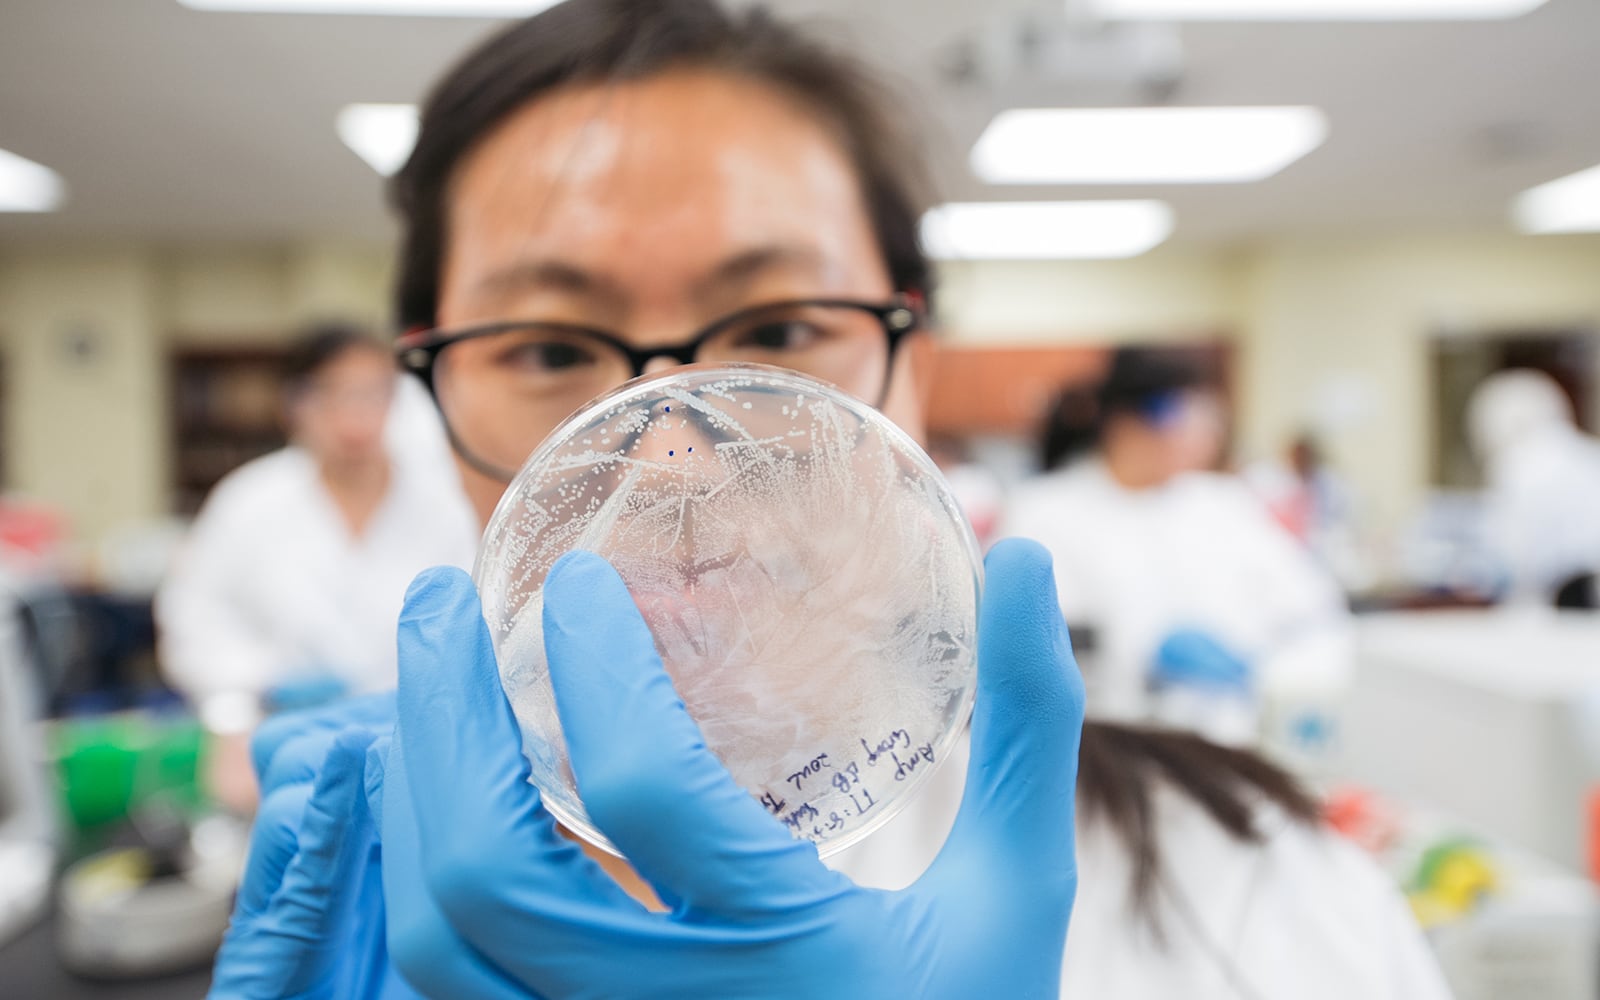

Academics
Make Your Mark.
At UAB, you’re free to be different, even in your studies. We offer a wide range of degree programs—150+ majors and minors, to be exact—to speak to your interests, spark your imagination, and help you make your unique mark on the world. You’re probably familiar with our healthcare and science accolades, but our arts, business, education, and professional degrees are just as strong. And, unlike traditional core classes, our Blazer Core curriculum puts you in real-world settings to gain valuable experience while connecting with your community. Because we believe you have to be different to make a difference.

Majors & Minors
We’re super proud of this tool. Don’t know what you want to study? Take a look at every major and minor—with program requirements, career options, the works. It's all laid out for you so you can start to plan your future.

Joint Heersink School of Medicine Programs
Our School of Medicine is well-known to the U.S. News & World Report ranking folks. So naturally, we paired our School of Medicine with our College of Arts and Sciences as well as our School of Engineering to offer a variety of programs.

Pre-professional Programs
Want to be a doctor? A dentist? An optometrist? A lawyer? Start preparing yourself during undergrad in one of our pre-professional tracks. Oh yeah, and if you’re more interested in veterinary medicine or pharmacy or something like that, we can tailor something just for you.

Honors and Scholars Programs
We’ve got some smart cookies here at UAB. People like you. That’s why we offer additional achievement opportunities. From Honors College to scholars' programs to fellowships and much more, there’s something here for you.

Early Acceptance Programs
You know where you want to go. You have the grades and test scores. So why wait? Get accepted into your desired program here at UAB.
Research
Research is really important to us. We rake in hundreds of millions of dollars every year for research and we rank high on the National Institutes of Health and other funding lists. Not only that—we’re eager to get you involved. We often let UAB freshman get in on the action, working alongside some of our most seasoned veterans.

Study Abroad
Did you know UAB is on all seven continents? It’s true. We really value the perspective you can get from an experience studying abroad. In fact, more than 100 of our programs offer this opportunity. Plus, we have scholarships available to help you afford it.

BlazerCore
UAB is redefining core classes. Blazer Core Curriculum is our innovative undergraduate general education track that emphasizes learning through experience, developing practical skills, and engaging with the community.
